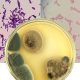
Describen las sinergias de combinar Trichoderma con bacterias para proteger y promover los cultivos

Describen las sinergias de combinar Trichoderma con bacterias para proteger y promover los cultivos
Combinar el hongo con bacterias como Bacillus y Pseudomonas tiene efectos sinérgicos al conseguir interacciones beneficiosas entre los microorganismos en el suelo y en las raíces de las plantas. Estas interacciones pueden llevar a aumentar la resistencia de las plantas a enfermedades, mejorar la capacidad de los microorganismos para colonizar las raíces, así como la estimulación del crecimiento y desarrollo de las plantas.
La agricultura sostenible es un tema crucial. Científicos de todo el mundo buscan soluciones para poner fin al uso excesivo de pesticidas químicos, tanto por sus consecuencias para la salud humana como la del ambiente. Para esto, se han propuesto diversas estrategias para reducir el uso de estos químicos y mejorar la producción de cultivos. Una de estas es el uso de agentes de biocontrol microbianos, los cuales se basan en el uso de microorganismos para controlar patógenos de plantas y mejorar el crecimiento y la salud de los cultivos, como hongos y bacerias.
Pero la estrategia no solo debe considerar usar estos microorganismos por separado. Un estudio realizado por los investigadores biológicos Jorge Poveda y Daniel Eugui, ambos de la Universidad Pública de Navarra, encontró que el uso combinado de estos microorganismos puede mejorar significativamente el crecimiento de las plantas, la absorción de nutrientes y la resistencia a patógenos. Así lo señalan en el paper titulado “Combined use of Trichoderma and beneficial bacteria (mainly Bacillus and Pseudomonas): Development of microbial synergistic bio-inoculants in sustainable agriculture“. En este documento exponen sus conclusiones tras investigar y recopilar los efectos sinérgicos de la combinación de Trichoderma y bacterias beneficiosas como Bacillus y Pseudomonas en la producción de cultivos.
“El uso combinado de Trichoderma y las bacterias beneficiosas en bioinoculantes puede resultar en efectos sinérgicos que mejoran el rendimiento y la calidad de los cultivos, reducen el uso de pesticidas químicos y promueven la agricultura sostenible”, escriben los autores.
Aseveran que hay efectos sinérgicos de los biocontroladores combinados pueden ser el resultado de interacciones beneficiosas entre los microorganismos en el suelo y en las raíces de las plantas. Estas interacciones pueden incluir la producción de compuestos que aumentan la resistencia de las plantas a enfermedades, la mejora de la capacidad de los microorganismos para colonizar las raíces de las plantas y la estimulación del crecimiento y desarrollo de las plantas.

En esta infografía, los autores Jorge Poveda y Daniel Eugui sintetizan el sistema de interacciones en la relación multitrófica entre planta, Trichoderma, bacterias benéficas y patógenos.
Explican que Trichoderma, por ejemplo, es capaz de secretar enzimas y metabolitos que inhiben el crecimiento de patógenos en el suelo, mientras que las bacterias beneficiosas producen compuestos antimicrobianos y regulan el sistema inmunológico de las plantas. El uso combinado de estos biocontroladores puede, por lo tanto, aumentar la capacidad de las plantas para resistir a patógenos y reducir la incidencia de enfermedades.
Además, los autores señalan que la presencia de bacterias beneficiosas también puede mejorar la capacidad de Trichoderma para colonizar las raíces de las plantas y protegerlas contra patógenos. Las bacterias beneficiosas pueden producir sustancias que atraen a Trichoderma a las raíces de las plantas y mejoran su capacidad para establecerse y multiplicarse en el suelo.
En segundo lugar, los autores destacan que el uso combinado de Trichoderma y bacterias beneficiosas también puede mejorar el crecimiento y desarrollo de las plantas. Trichoderma, por ejemplo, puede estimular el crecimiento de las raíces y aumentar la absorción de nutrientes, mientras que las bacterias beneficiosas pueden producir sustancias que promueven el crecimiento y la maduración de los frutos.
Concluyen en que el uso combinado de Trichoderma y bacterias beneficiosas en bioinoculantes puede ser una estrategia prometedora para la producción de alimentos sostenible. Los efectos sinérgicos entre estos microorganismos pueden mejorar significativamente el crecimiento de las plantas, la absorción de nutrientes y la resistencia a patógenos. Además, la producción de metabolitos secundarios y otros compuestos puede promover la defensa de las plantas contra los patógenos. Como se sugiere en el estudio, el uso de bioinoculantes microbianos que combinan Trichoderma y bacterias beneficiosas puede reducir la dependencia de los pesticidas químicos y promover el uso de microorganismos beneficiosos en los suelos agrícolas.
“Amplios estudios en la literatura demuestran cómo la combinación de Trichoderma y bacterias tiene potencial en la gestión agrícola, tanto como biofertilizante como biocontrolador”, dicen. “Sin embargo, se necesitan más estudios sobre el efecto de esta estrategia en la tolerancia al estrés abiótico en las plantas, y como BCA en el control de virus”.







